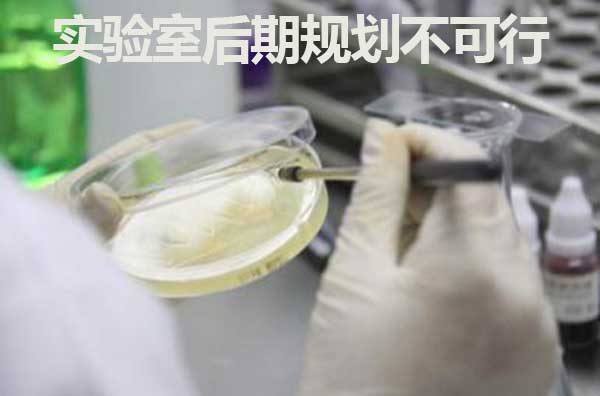
實(shí)驗(yàn)室后期規(guī)劃不可行

實(shí)驗(yàn)室后期規(guī)劃可行嗎?
日期:18-06-22 / 作者: 科瓦特小科 / 出處:科瓦特
今天我們來討論一下實(shí)驗(yàn)室后期規(guī)劃行不行的通的話題,接下來我們將從實(shí)驗(yàn)室承建方和實(shí)驗(yàn)室需求方,也就是我們通常說的甲方和乙方兩個(gè)方面來探討:
1.從實(shí)驗(yàn)室承建方來看實(shí)驗(yàn)室后期規(guī)劃可行嗎
如果是實(shí)驗(yàn)室承建方提出這樣的問題,首先你就是一個(gè)不合格的實(shí)驗(yàn)室承建商,大家如果碰到這樣的廠家就要注意了。但凡在實(shí)驗(yàn)室建設(shè)行業(yè)有點(diǎn)實(shí)力的,基本都是會(huì)先做實(shí)驗(yàn)室規(guī)劃,然后實(shí)驗(yàn)室設(shè)計(jì)在到實(shí)驗(yàn)室建設(shè)這么個(gè)流程來操作,為什么要這樣操作我想也不用在這贅述了。
2.從實(shí)驗(yàn)室需求方來看實(shí)驗(yàn)室后期規(guī)劃能否行的通
要是需求方提出這樣的問題,還是情有可原的,畢竟大多數(shù)需求方的人并不是實(shí)驗(yàn)室相關(guān)的專業(yè)人士。但對(duì)于甲方來講,實(shí)驗(yàn)室規(guī)劃提前做好的好處太多了,這對(duì)甲方是有利的。實(shí)驗(yàn)室規(guī)劃本身也屬于免費(fèi)的,一般不收費(fèi),應(yīng)當(dāng)是期望實(shí)驗(yàn)室規(guī)劃做的越專業(yè)越好,這樣雙方溝通起來很方便,也能促進(jìn)項(xiàng)目的順利開展,是保障實(shí)驗(yàn)室建設(shè)竣工的有力保障。
總之,通過本文,相信大家都是期望提前做好實(shí)驗(yàn)室規(guī)劃方案的,那更早與實(shí)驗(yàn)室規(guī)劃的實(shí)驗(yàn)室規(guī)劃草圖有沒有必要呢?小編一篇文章告訴您《實(shí)驗(yàn)室規(guī)劃草圖的重要性》。
熱門文章 Hot
- 能在線看的科學(xué)實(shí)驗(yàn)室建筑設(shè)計(jì)規(guī)范JGJ91-93新版-免費(fèi)下載01-13
- 無規(guī)則不成方圓,實(shí)驗(yàn)室裝修設(shè)計(jì)原則有哪些04-03
- 整體實(shí)驗(yàn)室設(shè)計(jì)需要注意什么08-28
- 實(shí)驗(yàn)室規(guī)劃需要注意的事項(xiàng)05-28
- 實(shí)驗(yàn)室設(shè)計(jì)需要遵循的原則有哪些04-18
- 實(shí)驗(yàn)室設(shè)計(jì)有哪些內(nèi)容02-22
- 生物實(shí)驗(yàn)室設(shè)計(jì)要求有哪些01-14
- 潔凈工程裝修要哪些材料?11-15
- 潔凈實(shí)驗(yàn)室設(shè)計(jì)規(guī)范都有哪些?11-08
- 實(shí)驗(yàn)室設(shè)計(jì)與建設(shè)有什么特別之處?10-24
相關(guān)內(nèi)容 Related
- 能在線看的科學(xué)實(shí)驗(yàn)室建筑設(shè)計(jì)規(guī)范JGJ91-93新版-免費(fèi)下載01-13
- 無規(guī)則不成方圓,實(shí)驗(yàn)室裝修設(shè)計(jì)原則有哪些04-03
- 整體實(shí)驗(yàn)室設(shè)計(jì)需要注意什么08-28
- 實(shí)驗(yàn)室規(guī)劃需要注意的事項(xiàng)05-28
- 實(shí)驗(yàn)室設(shè)計(jì)需要遵循的原則有哪些04-18
- 實(shí)驗(yàn)室設(shè)計(jì)有哪些內(nèi)容02-22
- 生物實(shí)驗(yàn)室設(shè)計(jì)要求有哪些01-14
- 潔凈工程裝修要哪些材料?11-15
- 潔凈實(shí)驗(yàn)室設(shè)計(jì)規(guī)范都有哪些?11-08
- 實(shí)驗(yàn)室設(shè)計(jì)與建設(shè)有什么特別之處?10-24
